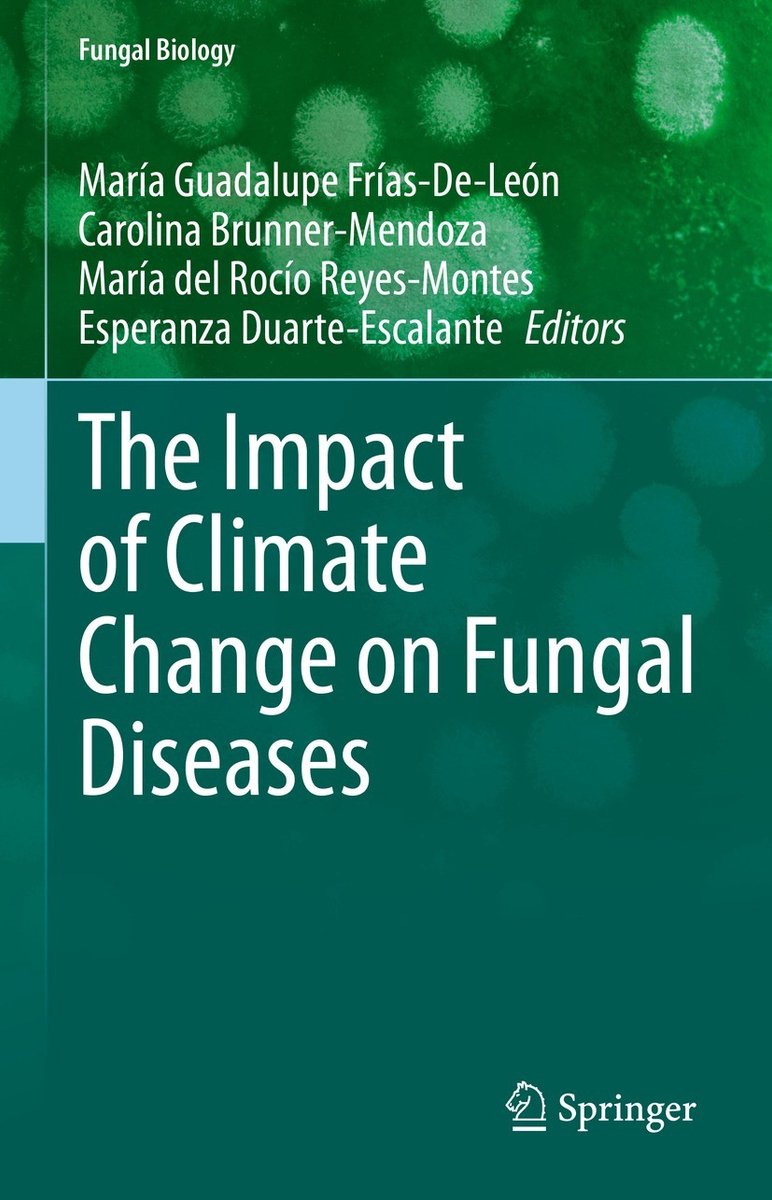

Type: Hardcover
ISBN: 9783030896638
Levertijd: 18
Aanbieder: